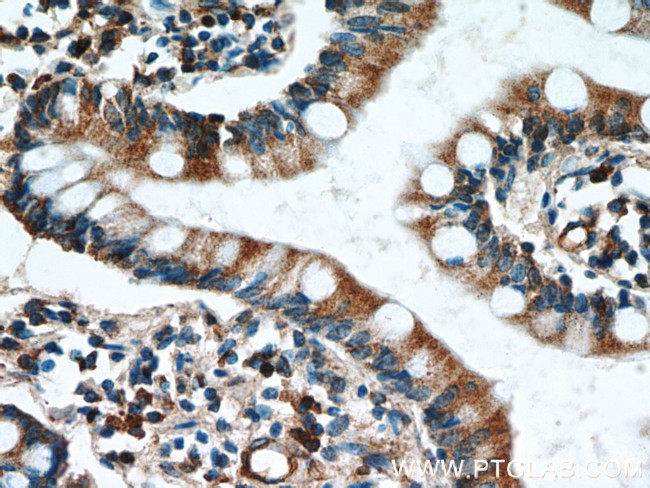
GCS1 Antibody in Immunohistochemistry (Paraffin) (IHC (P))
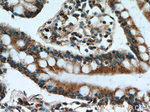
GCS1 Antibody in Immunohistochemistry (Paraffin) (IHC (P))
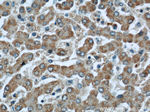
GCS1 Antibody in Immunohistochemistry (Paraffin) (IHC (P))

Search
Proteintech
GCS1 Polyclonal Antibody
{{$productOrderCtrl.translations['antibody.pdp.commerceCard.promotion.promotions']}}
{{$productOrderCtrl.translations['antibody.pdp.commerceCard.promotion.viewpromo']}}
{{$productOrderCtrl.translations['antibody.pdp.commerceCard.promotion.promocode']}}: {{promo.promoCode}} {{promo.promoTitle}} {{promo.promoDescription}}. {{$productOrderCtrl.translations['antibody.pdp.commerceCard.promotion.learnmore']}}
产品信息
17859-1-AP
种属反应
宿主/亚型
分类
类型
抗原
偶联物
形式
浓度
规格
纯化类型
保存液
内含物
保存条件
运输条件
产品详细信息
Immunogen sequence: DEARARVPP EFLVQRAVHA NPPTLLLPVA HMLEVGDPDD LAFLRKALPR LHAWFSWLHQ SQAGPLPLSY RWRGRDPALP TLLNPKTLPS GLDDYPRASH PSVTERHLDL RCWVALGARV LTRLAEHLGE AEVAAELGPL AASLEAAESL DELHWAPELG VFADFGNHTK AVQLKPRPPQ GLVRVVGRPQ PQLQYVDALG YVSLFPLLLR LLDPTSSRLG PLLDILADSR HLWSPFGLRS LAASSSFYGQ RNSEHDPPYW RGAVWLNVNY LALGALHHYG HLEGPHQARA AKLHGELRAN VVGNVWRQYQ ATGFLWEQYS DRDGRGMGCR PFHGWTSLVL LAMAEDY (492-837 aa encoded by BC028337 )
靶标信息
GCS1 cleaves the distal alpha 1,2-linked glucose residue from the Glc(3)Man(9)GlcNAc(2) oligosaccharide precursor in a highly specific manner. Defects in GCS1 are the cause of type IIb congenital disorder of glycosylation (CDGIIb). This syndrome is also known as glucosidase I deficiency and is characterized by marked generalized hypotonia and hypomotility of the neonate, dysmorphic features, including a prominent occiput, short palpebral fissures, retrognathia, high arched palate, generalized edema, and hypoplastic genitalia. Symptoms include hepatomegaly, hypoventilation, feeding problems and seizures. The clinical course is progressive and survival is at most a few months.
仅用于科研。不用于诊断过程。未经明确授权不得转售。
生物信息学
蛋白别名: Endoplasmic reticulum alpha-glucosidase I; epididymis secretory sperm binding protein; ER glu I; Glucosidase 1; glucosidase I; Glycoprotein-processing glucosidase I; Mannosyl-oligosaccharide glucosidase; Processing A-glucosidase I; unnamed protein product
基因别名: 1810017N02Rik; AI181835; CDG2B; CWH41; DER7; GCS1; MOGS
UniProt ID: (Human) Q13724, (Mouse) Q80UM7
Entrez Gene ID: (Human) 7841, (Mouse) 57377